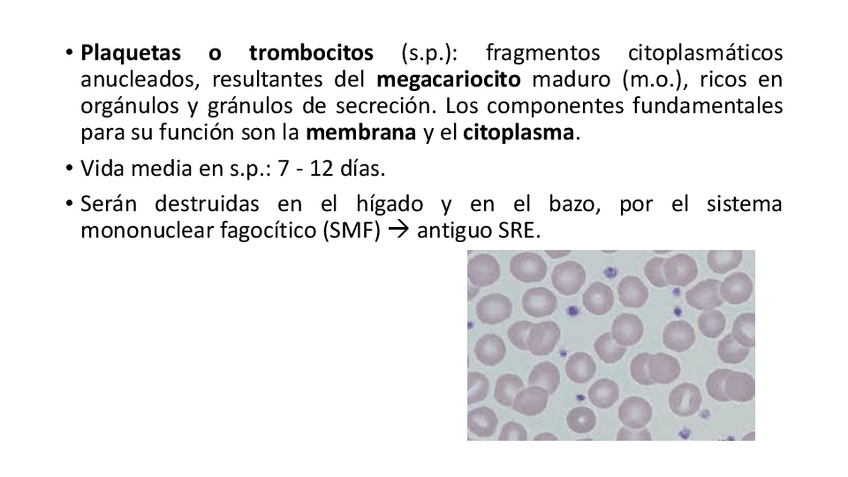

@pumpkinmartie
65 Publicaciones
678 Interacciones
6 Seguidores
2 Siguiendo
Lista de publicaciones de pumpkinmartie
He publicado nuevos apuntes de Técnicas de análisis hematológico: tema-sobre-las-plaquetas-y-lo-relacionado-a-estas.pdf
He publicado nuevos apuntes de Técnicas de inmunodiagnóstico: tema-5-valoracion-de-la-funcionalidad-de-la-inmunidad-celular.pdf
He publicado nuevos apuntes de Microbiología Clínica: Tabla-de-pruebas-bioquimicas.pdf
He publicado nuevos apuntes de Microbiología Clínica: tema-4-bacteriologia.pdf
He publicado nuevos apuntes de Técnicas de análisis hematológico: tema-5-analisis-hematologico-de-la-serie-blanca-neoplasias-hematopoyeticas.pdf
He publicado nuevos apuntes de Análisis Bioquímico: tema-6-determinacion-de-enzimas.pdf
He publicado nuevos apuntes de Técnicas de inmunodiagnóstico: tema-3-tecnicas-basadas-en-reacciones-Ag-Ac-primarias.pdf
He publicado nuevos apuntes de Microbiología Clínica: tema-6-bacteriologia-estudio-de-las-muestras-biologicas.pdf
He publicado nuevos apuntes de Técnicas de análisis hematológico: tema-4-analisis-hematologico-de-la-serie-roja-eritropatologia.pdf
He publicado nuevos apuntes de Microbiología Clínica: tema-3-bacteriologia-tecnicas-de-cultivo-aislamiento-y-recuento.pdf
He publicado nuevos apuntes de Análisis Bioquímico: tema-4-magnitudes-de-productos-finales-del-metabolismo.pdf
He publicado nuevos apuntes de Técnicas de inmunodiagnóstico: tema-2-tecnicas-basadas-en-las-reacciones-Ag-Ac-secundarias.pdf
He publicado nuevos apuntes de Técnicas de inmunodiagnóstico: tema-1-las-tecnicas-inmunologicas.pdf
He publicado nuevos apuntes de Análisis Bioquímico: tema-3-metabolismo-de-principios-inmediatos.pdf
He publicado nuevos apuntes de Técnicas de análisis hematológico: tema-3-recuentos-celulares-el-hemograma.pdf
He publicado nuevos apuntes de Microbiología Clínica: tema-2-bacteriologia-tecnicas-de-tincion-y-observacion-de-bacterias.pdf
He publicado nuevos apuntes de Microbiología Clínica: tema-1-la-microbiologia.pdf
He publicado nuevos apuntes de Técnicas de análisis hematológico: tema-2-estudio-morfologico-de-celulas-sanguineas-en-sangre-periferica-y-medula-osea.pdf
He publicado nuevos apuntes de Técnicas de análisis hematológico: tema-1-tecnicas-de-analisis-hematologico.pdf
He publicado nuevos apuntes de Análisis Bioquímico: tema-2-tecnicas-de-laboratorio-de-bioquimica-clinica-II.pdf